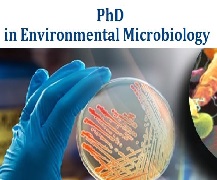

Ph.D. in English takes approximately 5-7 years to accomplish, depending on the program and individual progress. This postgraduate degree emphasizes in-depth study of literature, language, and critical theory. Students conduct substantial research, culminating in a PhD dissertation that adds novel knowledge to the discipline. The curriculum frequently includes coursework, extensive tests, and teaching obligations. Specializations may include medieval literature, postcolonial studies, and digital humanities. Graduates get opportunities for positions in academia, publishing, and advanced research. The degree needs a solid basis in literary interpretation, exceptional writing skills, and the capacity to perform independent scholarly research.
Ph.D. in History
Ph.D. in History takes approximately 5-7 years to accomplish, depending on the program and individual development. This advanced degree requires extensive research, critical analysis, and an origin...
Ph.D. in History
×Ph.D. in History takes approximately 5-7 years to accomplish, depending on the program and individual development. This advanced degree requires extensive research, critical analysis, and an original contribution to historical knowledge. Students participate in coursework, comprehensive exams, and dissertation writing. The program encompasses history, research methodology, and specific fields of study. Candidates become proficient in primary source analysis, archival research, and academic writing. The climax is a doctoral dissertation that presents novel research findings. This degree provide different career positions in academia, research institutes, museums, and other professions that require extensive historical knowledge. Successful completion indicates mastery of historical study and the ability to add to the field's corpus of knowledge.
Ph.D. in Geography
Ph.D. in Geography normally takes 3-5 years to complete, depending on the university and research area. This postgraduate degree focuses on complex spatial linkages, human-environmental interaction...
Ph.D. in Geography
×Ph.D. in Geography normally takes 3-5 years to complete, depending on the university and research area. This postgraduate degree focuses on complex spatial linkages, human-environmental interactions, and geographical theories. Students complete demanding coursework, exhaustive tests, and original research, culminating in a dissertation. The program includes a wide range of topics, including physical geography, human geography, and geospatial technology. Candidates gain experience in research methods, data analysis, and critical thinking. Graduates get the opportunity to work in academics, environmental consultancy, urban development, and government agencies. The Ph.D. program encourages a thorough awareness of global concerns, spatial patterns, and the interconnection of human and ecological systems of all sizes.
Ph.D. in Economics
Ph.D. in Economics takes approximately 4-6 years to complete, depending on the program and individual success. The degree requires advanced study of economic theory, quantitative methods, and speci...
Ph.D. in Economics
×Ph.D. in Economics takes approximately 4-6 years to complete, depending on the program and individual success. The degree requires advanced study of economic theory, quantitative methods, and specific subjects such as macroeconomics, microeconomics, econometrics, and development economics. Students complete demanding coursework, thorough tests, and original research, culminating in a PhD dissertation. This degree provides different career positions in academia, research institutes, government agencies, and the business sector that require advanced economic analysis. Data analysis, mathematical modeling, critical thinking, and the capacity to undertake independent study on complicated economic issues are all important abilities learned.
Ph.D. in Education
Ph.D. in Education usually requires 3-5 years for completion, depending on the program and whether the student pursues full-time or part-time. This advanced degree emphasizes educational research,...
Ph.D. in Education
×Ph.D. in Education usually requires 3-5 years for completion, depending on the program and whether the student pursues full-time or part-time. This advanced degree emphasizes educational research, philosophical thought, and practice. Students take hard courses, perform original research, and submit a dissertation. The curriculum frequently includes educational psychology, curriculum creation, educational policy, and research methodology. Graduates are equipped for positions in academia, educational leadership, policymaking, and advanced research. This degree needs a master's degree for admission and concludes in a comprehensive examination followed by an effective doctoral defense before a committee of academic experts.
Ph.D. in Mechanical Engineering
Ph.D. in Mechanical Engineering takes around 4-6 years to complete, depending on the university and research project. This advanced degree focuses on developing cutting-edge knowledge in fields suc...
Ph.D. in Mechanical Engineering
×Ph.D. in Mechanical Engineering takes around 4-6 years to complete, depending on the university and research project. This advanced degree focuses on developing cutting-edge knowledge in fields such as robotics, thermodynamics, fluid mechanics, materials science, and control systems. Students take challenging courses, perform unique research, and complete a PhD dissertation. The curriculum promotes problem-solving, critical thinking, and innovative abilities, preparing graduates to take on leadership roles in academia, industry, or research organizations. Ph.D. candidates usually collaborate on interdisciplinary projects, publish in peer-reviewed journals, and give presentations at conferences, all of which contribute to growth in sectors such as renewable energy, aerospace, automotive engineering, and biomedical devices.
Ph.D. in Computer Science And Engineering
Ph.D. in Computer Science and Engineering usually requires 4-6 years to attain, depending on the university and the stage of the study. This advanced degree focuses cutting-edge research in f...
Ph.D. in Computer Science And Engineering
×Ph.D. in Computer Science and Engineering usually requires 4-6 years to attain, depending on the university and the stage of the study. This advanced degree focuses cutting-edge research in fields such as artificial intelligence, machine learning, cybersecurity, computer networks, and software engineering. Students take tough courses, perform unique research, and submit a dissertation under faculty supervision. The program of study encourages skill in problem-solving, critical thinking, and innovation in the sector. Graduates are prepared to work in academia, research labs, or high-level positions within the technology business. Admission usually requires a master's degree in a related discipline, an impressive academic record, and research potential. Teaching or research fellowships are common sources for funding.
Ph.D. in Electronics And Communication Engineering
Ph.D. in Electronics and Communication Engineering generally takes 3-5 years to complete, depending on the university and the level of the study. This advanced degree focuses the latest development...
Ph.D. in Electronics And Communication Engineering
×Ph.D. in Electronics and Communication Engineering generally takes 3-5 years to complete, depending on the university and the level of the study. This advanced degree focuses the latest developments in signal processing, wireless communications, microelectronics, and embedded systems. Students undertake challenging courses, implement original research, and write their dissertations under faculty supervision. The program promotes skills in developing complex electronic systems, creating innovative communication technologies, and addressing real-world engineering challenges. Graduates are well-prepared to work in academia, research institutions, or high-tech enterprises, helping to improve disciplines such as 5G/6G networks, IoT, artificial intelligence, and quantum computing. This degree involves strong analytical skills, creativity, and an intense passion for technological advancement.
Ph.D. in Electrical Engineering
Ph.D. in Electrical Engineering generally requires 4-6 years to complete, depending on a master's degree. This advanced degree emphasizes cutting-edge research and specific fields like signal p...
Ph.D. in Electrical Engineering
×Ph.D. in Electrical Engineering generally requires 4-6 years to complete, depending on a master's degree. This advanced degree emphasizes cutting-edge research and specific fields like signal processing, power systems, and telecommunications. Candidates take challenging courses, perform distinctive research, and defend a dissertation. Advanced mathematics, electromagnetic theory, and computer engineering are common topics in the curriculum. Graduates possess the skills for job opportunities in academia, research institutes, and high-tech business organizations. This degree desires strong analytical abilities, creativity, and tenacity. It provides opportunity to contribute to technological developments and solve complicated engineering challenges, making it a lucrative career path for those who enjoy innovation in electrical systems and technology.
Ph.D. in Civil Engineering
A Ph.D. in Civil Engineering typically requires 3-5 years to complete, depending on the university and research area. This graduate degree program emphasizes particular fields such as structural en...
Ph.D. in Civil Engineering
×A Ph.D. in Civil Engineering typically requires 3-5 years to complete, depending on the university and research area. This graduate degree program emphasizes particular fields such as structural engineering, geotechnical engineering, transportation systems, environmental engineering, and water resource management. Students take difficult courses, do unique research, and write a doctoral thesis that adds new understanding to the area. The program of study addresses advanced analytical abilities, research approaches, and problem-solving techniques applicable to difficult civil engineering tasks. Graduates are prepared for managerial roles in academia, research institutes, government agencies, or the commercial sector, where they can drive innovation in building infrastructure, sustainability, and urban planning.
Ph.D. in Law
The highest academic degree in legal studies is the Ph.D. in Law, generally requires 3-5 years to complete. This challenging program emphasizes advanced legal research, theory, and scholarly...
Ph.D. in Law
×The highest academic degree in legal studies is the Ph.D. in Law, generally requires 3-5 years to complete. This challenging program emphasizes advanced legal research, theory, and scholarly writing. Candidates select a specific topic of law for a comprehensive study and innovative contribution to legal knowledge. The curriculum consists of coursework, comprehensive exams, and the production of a doctoral dissertation with faculty supervision. Students acquire knowledge of legal analysis, research methods, and academic writing. A Ph.D. in Law prepares graduates for a position in academia, legal research, policymaking, or senior positions in law firms and organizations. Admission generally requires an elementary law degree (J.D. or LL.M.) along with suitable experience.
Ph.D. in Management
Ph.D. in Management typically requires 4-6 years to complete, depending on the university and the student's progress. This postgraduate degree program focuses on enhancing awareness of manageme...
Ph.D. in Management
×Ph.D. in Management typically requires 4-6 years to complete, depending on the university and the student's progress. This postgraduate degree program focuses on enhancing awareness of management theory, research methods, and organizational behavior. Students pursue demanding coursework, thorough tests, and original research, culminating in a PhD dissertation. Strategic management, leadership, organizational psychology, and advanced statistics are common themes in the curriculum. Graduates are equipped for jobs in academia, research institutions, or high-level consultancy positions. The curriculum demands a good academic background, which typically includes a master's degree, and stresses critical thinking, analytical skills, and the ability to contribute new information to the field of management.
Ph.D. in Journalism And Mass Communication
Ph.D. in Journalism and Mass Communication usually takes 3-5 years to complete, depending on the program and research requirements. This postgraduate degree emphasizes in-depth research and a...
Ph.D. in Journalism And Mass Communication
×Ph.D. in Journalism and Mass Communication usually takes 3-5 years to complete, depending on the program and research requirements. This postgraduate degree emphasizes in-depth research and analysis of media, communication theories, and their societal implications. Students pursue challenging courses, conduct independent research, and often serve as teaching assistants. The program culminates with a doctoral dissertation, which contributes new information to the regulation. Graduates have the abilities to work in academia, advanced research, media policy, or as leaders in media organizations. Digital media technology, media ethics, global communication, data journalism, and emerging trends in mass communication may all be important topics to research.
Ph.D. in Biochemistry
A Ph.D. in Biochemistry normally takes 4-6 years to complete, with a concentration on the chemical processes found within and related to living organisms. This advanced degree needs intensive labor...
Ph.D. in Biochemistry
×A Ph.D. in Biochemistry normally takes 4-6 years to complete, with a concentration on the chemical processes found within and related to living organisms. This advanced degree needs intensive laboratory research, data analysis, and the creation of a unique thesis. Students analyze molecular biology, enzymology, and cellular metabolism. The program often involves coursework, teaching assistantships, and the publication of research publications. Graduates have the ability to pursue careers in academia, pharmaceutical research, biotechnology, and allied fields. The doctoral program develops critical thinking, problem-solving abilities, and the ability to design and conduct autonomous research, resulting in important contributions to the field of biochemistry and related life sciences.
Ph.D. in Mathematics
Ph.D. in Mathematics is a terminal degree that usually requires 4-7 years to accomplish after acquiring a bachelor's degree. The curriculum comprises advanced coursework in pure and appli...
Ph.D. in Mathematics
×Ph.D. in Mathematics is a terminal degree that usually requires 4-7 years to accomplish after acquiring a bachelor's degree. The curriculum comprises advanced coursework in pure and applied mathematics, as well as independent research that leads to the completion of a doctorate research. PhD students acquire proficiency in abstract algebra, real and complex analysis, topology, and discrete mathematics. The degree prepares graduates for academic careers as university professors and researchers, as well as jobs in industries such as banking, technology, and government that require strong quantitative and problem-solving abilities.
Ph.D. in Bioinformatics
The Ph.D. in Bioinformatics is a 4-5 year advanced research-oriented program that offers comprehensive training in the interdisciplinary subject of computational biology. The program includes parts...
Ph.D. in Bioinformatics
×The Ph.D. in Bioinformatics is a 4-5 year advanced research-oriented program that offers comprehensive training in the interdisciplinary subject of computational biology. The program includes parts such as genomics, proteomics, systems biology, machine learning, and high-performance computing. Independent research projects, laboratory work, and collaborations with industry and academia help students acquire competence in building unique computer algorithms, developing advanced data analysis tools, and applying them to challenging biological challenges. Graduates of this program are trained to work as bioinformatics scientists, computational biology researchers, data scientists, and faculty members in universities and research institutions at the forefront of bioinformatics and computational life sciences.
Ph.D. in Toxicology
Ph.D. in Toxicology typically takes 3 - 5 years to complete and focuses on the study of harmful substances and their effects on living organisms. The program encompasses a range of disciplines, inc...
Ph.D. in Toxicology
×Ph.D. in Toxicology typically takes 3 - 5 years to complete and focuses on the study of harmful substances and their effects on living organisms. The program encompasses a range of disciplines, including biology, chemistry, pharmacology, and environmental science. Students engage in advanced coursework, and laboratory research, and often complete a dissertation based on original research in areas such as drug toxicity, environmental toxicology, or risk assessment. This degree prepares graduates for careers in academia, industry, regulatory agencies, or public health, where they contribute to understanding and mitigating the risks associated with toxic substances.
Ph.D. in Nanobiotechnology
Ph.D. in Nanobiotechnology typically spans 3 - 5 years and combines the principles of nanotechnology and biotechnology to explore innovative solutions for biomedical applications. This i...
Ph.D. in Nanobiotechnology
×Ph.D. in Nanobiotechnology typically spans 3 - 5 years and combines the principles of nanotechnology and biotechnology to explore innovative solutions for biomedical applications. This interdisciplinary program covers areas such as nanoscale materials, drug delivery systems, biosensors, and biomolecular engineering. Students engage in cutting-edge research, utilizing techniques like nanofabrication, imaging, and molecular biology. Coursework may include advanced topics in nanotechnology, molecular biology, and bioinformatics, alongside hands-on laboratory work. Graduates are prepared for careers in academia, research institutions, and industry sectors focused on pharmaceuticals, diagnostics, and environmental applications, contributing to advancements in healthcare and materials science.
Ph.D. in Business Administration
Ph.D. in Business Administration normally takes 3-5 years and focuses on advanced research approaches and theoretical frameworks in a variety of business fields, including management, fi...
Ph.D. in Business Administration
×Ph.D. in Business Administration normally takes 3-5 years and focuses on advanced research approaches and theoretical frameworks in a variety of business fields, including management, finance, marketing, and organizational behavior. The program frequently demands the completion of core courses, rigorous tests, and a dissertation that provides original information about the discipline. Students conduct in-depth studies and analyses of current business difficulties, preparing them for academic, research, and high-level consulting positions. Admission often requires a suitable master's degree, a strong academic record, and research proposals that outline a clear vision for future research interests.
Ph.D. in Statistics
Ph.D. in Statistics typically spans 4 - 6 years and involves advanced coursework in statistical theory, methodology, and application. The program often includes courses in multivariate analysi...
Ph.D. in Statistics
×Ph.D. in Statistics typically spans 4 - 6 years and involves advanced coursework in statistical theory, methodology, and application. The program often includes courses in multivariate analysis, Bayesian statistics, statistical modeling, and data mining. Students are expected to conduct original research, culminating in a dissertation that contributes new knowledge to the field. Ph.D. candidates may also participate in teaching and mentoring undergraduate students. Admission usually requires a strong background in mathematics and statistics, along with GRE scores and letters of recommendation. Graduates often pursue careers in academia, industry, or government, focusing on data analysis, research, and statistical consulting.
Ph.D. in Nanoscience and Technology
A Ph.D. in Nanoscience and Technology is a research-based program that focuses on the study and application of nanomaterials and nanotechnology, as well as their integration into industries like el...
Ph.D. in Nanoscience and Technology
×A Ph.D. in Nanoscience and Technology is a research-based program that focuses on the study and application of nanomaterials and nanotechnology, as well as their integration into industries like electronics, energy, and medicine. The program typically lasts 3-5 years and covers topics such as nanomaterial production, characterisation techniques, quantum mechanics, and nanofabrication. Students conduct cutting-edge research to create new nanoscale materials and investigate their potential applications in areas such as medication delivery, sensors, and renewable energy. In most cases, admission requires a Master's degree in Physics, Chemistry, Materials Science, or a related field. Graduates work in academia, research institutes, or enterprises that focus on nanotechnology and innovation.
Ph.D. in Clinical Genomics
A Ph.D. in Clinical Genomics is a research program that focuses on the use of genomic technology to better understand hereditary disorders, disease processes, and personalized therapy. The program...
Ph.D. in Clinical Genomics
×A Ph.D. in Clinical Genomics is a research program that focuses on the use of genomic technology to better understand hereditary disorders, disease processes, and personalized therapy. The program typically lasts 3 to 5 years and includes advanced studies in genomics, bioinformatics, molecular biology, and clinical research. Students perform research on genetic testing, gene therapy, and the significance of genetic variation in diseases such as cancer, heart disease, and neurological problems. In most cases, admission needs a Master's degree in genetics, biotechnology, or a related discipline. Graduates contribute to clinical research, diagnostics, and healthcare by working at hospitals, research institutions, or biotechnology companies.
Ph.D. in Immunology
A Ph.D. in Immunology is a research-oriented program that investigates the immune system, including cellular and molecular mechanisms, immunological responses, and the role of immunity in disease....
Ph.D. in Immunology
×A Ph.D. in Immunology is a research-oriented program that investigates the immune system, including cellular and molecular mechanisms, immunological responses, and the role of immunity in disease. The curriculum typically lasts 3 to 5 years and covers topics such as immunogenetics, autoimmune disorders, immunotherapy, vaccinations, and cancer immunology. Students do experimental research, using techniques such as flow cytometry, molecular biology, and cell culture to investigate immunological functions and interactions. In general, admission requires a Master's degree in Immunology, Biochemistry, or a closely related subject. Graduates pursue positions in academic research, biotechnology, pharmaceuticals, or healthcare, helping to promote immunotherapy and vaccine development.
Ph.D. in Protein Chemistry
A Ph.D. in Protein Chemistry is a research-based program that studies the structure, function, and interactions of proteins. The program typically lasts 3 to 5 years and covers topics like as prote...
Ph.D. in Protein Chemistry
×A Ph.D. in Protein Chemistry is a research-based program that studies the structure, function, and interactions of proteins. The program typically lasts 3 to 5 years and covers topics like as protein folding, enzymology, post-translational modifications, and protein-protein interactions. Students conduct experimental and computational studies to better understand protein behavior and its roles in cellular processes, disease mechanisms, and biotechnology applications. In general, admission requires a Master's degree in Chemistry, Biochemistry, or a related subject. Graduates make contributions to subjects such as drug discovery, biotechnology, and structural biology, working in academic, pharmaceutical, and industrial settings.
Ph.D. in Environmental Microbiology
A Ph.D. in Environmental Microbiology is a research-intensive program that investigates the function of microorganisms in environmental processes such as bioremediation, nutrient cycling, and ecosy...
Ph.D. in Environmental Microbiology
×A Ph.D. in Environmental Microbiology is a research-intensive program that investigates the function of microorganisms in environmental processes such as bioremediation, nutrient cycling, and ecosystem health. The curriculum typically lasts 3 to 5 years and covers topics such as microbial ecology, environmental biotechnology, soil and water microbiology, and microbial interactions in natural environments. Students undertake original research to determine how bacteria affect environmental sustainability and pollution management. Admission typically requires a Master's degree in Microbiology, Environmental Science, or a related discipline. Graduates work in academia, environmental consulting, or industries related to waste management, water treatment, and environmental conservation.
Ph.D. in Microbial Physiology
A Ph.D. in Microbial Physiology is a research-based program that studies the metabolic processes and physiological systems of microorganisms. The program typically lasts 3 to 5 years and covers top...
Ph.D. in Microbial Physiology
×A Ph.D. in Microbial Physiology is a research-based program that studies the metabolic processes and physiological systems of microorganisms. The program typically lasts 3 to 5 years and covers topics such as microbial development, metabolism, environmental adaptation, and microbial interactions. Students do experimental study to better understand how microorganisms respond to various situations, such as stress, nutrition availability, and pathogenic habitats. In most cases, admission needs a Master's degree in microbiology, biochemistry, or a related subject. Graduates make contributions to subjects such as medical microbiology, biotechnology, environmental science, and industrial applications, working in academic research, healthcare, or biotechnology.
Ph.D. in Molecular Genetics & Population Genetics
A Ph.D. in Molecular Genetics & Population Genetics is a research-oriented program that investigates the genetic basis of inheritance, evolution, and population dynamics at the molecular level....
Ph.D. in Molecular Genetics & Population Genetics
×A Ph.D. in Molecular Genetics & Population Genetics is a research-oriented program that investigates the genetic basis of inheritance, evolution, and population dynamics at the molecular level. The curriculum, which typically lasts 3-5 years, combines molecular biology, genomics, and statistical genetics to investigate gene function, genetic variation, and evolutionary processes in populations. Students conduct research on gene mapping, population structure, genetic diversity, and evolutionary theory. Admission usually requires a Master's degree in Genetics, Biology, or a related discipline. Graduates pursue professions in academic research, biotechnology, conservation biology, and public health genetics.
Ph.D. in Phytochemistry
A Ph.D. in Phytochemistry is a research-oriented program that examines the chemical characteristics and biological activity of plant-derived substances. The curriculum typically lasts 3-5years and...
Ph.D. in Phytochemistry
×A Ph.D. in Phytochemistry is a research-oriented program that examines the chemical characteristics and biological activity of plant-derived substances. The curriculum typically lasts 3-5years and covers topics such as plant metabolites, secondary metabolites, extraction methodologies, and bioactivity testing. Students conduct advanced research to find, isolate, and characterize plant chemicals, with a focus on their potential uses in pharmaceuticals, agriculture, and natural product chemistry. In most cases, admission needs a Master's degree in Chemistry, Biochemistry, or a similar subject. Graduates work in academia, pharmaceutical businesses, research institutions, and sectors related to natural goods and sustainable medicine.
Ph.D. in Ecology
A Ph.D. in Ecology is a research-based program that studies ecosystems, biodiversity, and organism-environment interactions. The curriculum typically lasts 3 to 5 years and covers topics such as po...
Ph.D. in Ecology
×A Ph.D. in Ecology is a research-based program that studies ecosystems, biodiversity, and organism-environment interactions. The curriculum typically lasts 3 to 5 years and covers topics such as population dynamics, conservation biology, ecosystem services, and environmental change. Students do fieldwork and laboratory research to understand ecological processes and the effects of human activity on ecosystems. Admission needs a Master's degree in ecology, biology, or a related discipline. Graduates work in academia, research institutions, government agencies, or non-governmental organizations to support environmental management, conservation efforts, policy formulation, and sustainability programs.
Ph.D. in Human Physiology
A Ph.D. in Human Physiology is a research-based program that delves into the complex processes and systems of the human body at the molecular, cellular, and systemic levels. The program typically l...
Ph.D. in Human Physiology
×A Ph.D. in Human Physiology is a research-based program that delves into the complex processes and systems of the human body at the molecular, cellular, and systemic levels. The program typically lasts 3-5years and covers topics such as cardiovascular physiology, neurophysiology, metabolic processes, and endocrine regulation. Students carry out cutting-edge research, frequently concentrating on illness causes, health issues, and biological applications. Admission typically requires a Master's degree in Physiology, Biology, or a related subject. Graduates are equipped to work in academic research, clinical physiology, healthcare, or pharmaceutical businesses, helping to enhance medical science and human health.
Ph.D. in Supramolecular Chemistry
A Ph.D. in Supramolecular Chemistry focuses on the non-covalent interactions between molecules that result in complex, structured structures with distinct features. The program is typically 3 to 5...
Ph.D. in Supramolecular Chemistry
×A Ph.D. in Supramolecular Chemistry focuses on the non-covalent interactions between molecules that result in complex, structured structures with distinct features. The program is typically 3 to 5 years long and covers topics such as host-guest chemistry, molecular recognition, self-assembly, and functional material design. Students conduct both theoretical and experimental research, investigating applications in medication administration, sensing, and catalysis. In most cases, admission requires a Master's degree in Chemistry or a related subject. Graduates of this curriculum enhance nanotechnology, material science, and biochemistry by pursuing positions in academia, research institutes, or the pharmaceutical and chemical businesses.
Ph.D. in Nanomaterial Chemistry
A Ph.D. in Nanomaterial Chemistry is a research-oriented program that focuses on the design, synthesis, and characterisation of nanomaterials with distinct properties for use in a variety of sector...
Ph.D. in Nanomaterial Chemistry
×A Ph.D. in Nanomaterial Chemistry is a research-oriented program that focuses on the design, synthesis, and characterisation of nanomaterials with distinct properties for use in a variety of sectors, including electronics, energy, and medicine. This program typically lasts 3 to 5 years and covers advanced topics such as nanostructure production, surface chemistry, quantum mechanics, and nanomaterial characterization techniques. Students perform unique research to create new nanomaterials with increased functionality and investigate their potential applications in sensors, medication delivery, and renewable energy. In most cases, admission requires a M. Sc in Chemistry or a related subject. Graduates work in academia, research institutions, and enterprises that use sophisticated materials.
Ph.D. in Asymmetric Synthesis
A Ph.D. in Asymmetric Synthesis is a research-intensive program aimed at developing methods for producing chiral compounds with great precision and selectivity. The program typically lasts 3 to 5 y...
Ph.D. in Asymmetric Synthesis
×A Ph.D. in Asymmetric Synthesis is a research-intensive program aimed at developing methods for producing chiral compounds with great precision and selectivity. The program typically lasts 3 to 5 years and covers advanced topics like as stereochemistry, reaction processes, catalysis, and the synthesis of complex, physiologically active molecules. Students conduct cutting-edge research to create new synthetic techniques that are critical for medicines, agrochemicals, and materials science. In most cases, admission requires a Master's degree in Chemistry or a related subject. Graduates of this program contribute to advances in medicine design, chemical manufacture, and other industries that use chiral compounds.
Ph.D. in Organic Synthesis
A Ph.D. in Organic Synthesis is a research-oriented program that investigates the design and production of organic compounds using chemical reactions. This program, which typically lasts 3-5 y...
Ph.D. in Organic Synthesis
×A Ph.D. in Organic Synthesis is a research-oriented program that investigates the design and production of organic compounds using chemical reactions. This program, which typically lasts 3-5 years, focuses on advanced investigations in reaction mechanisms, catalysis, and the creation of new synthetic methods for medicines, materials, and bioactive molecules. Students perform novel research, frequently with the goal of enhancing synthesis pathways, efficiency, and sustainability in organic chemistry. Admission requires a master's degree in chemistry or a related subject. Graduates of the program often work in academia, the pharmaceutical industry, or chemical research, contributing to advances in drug discovery and materials science.
Ph.D. in Astrophysics
Studying celestial bodies, cosmic phenomena, and the fundamental physics of the cosmos is the focus of a Ph.D. program in astrophysics, which is research-oriented. The curriculum, which usually las...
Ph.D. in Astrophysics
×Studying celestial bodies, cosmic phenomena, and the fundamental physics of the cosmos is the focus of a Ph.D. program in astrophysics, which is research-oriented. The curriculum, which usually lasts 3-5 years, blends theoretical work with practical research in fields such as high-energy astrophysics, galaxy formation, black holes, cosmology, and stellar evolution. Students explore the basic forces of nature using sophisticated computational techniques, observatories, and simulations. A master's degree in physics or a similar discipline is often required for admission. Program graduates go on to work in academia, research facilities, and space organizations, furthering our knowledge of the cosmos overall.
Ph.D. in Material Science
The study of materials, including their characteristics, composition, and functionality, is the main focus of a research-driven Ph.D. program in material science. This program, which usually lasts...
Ph.D. in Material Science
×The study of materials, including their characteristics, composition, and functionality, is the main focus of a research-driven Ph.D. program in material science. This program, which usually lasts 3-5 years, covers subjects such advanced manufacturing techniques, semiconductors, polymers, nanomaterials, and biomaterials. Students investigate material behavior at the atomic and molecular level through theoretical and experimental study, with applications in engineering, electronics, and energy storage. A Master's degree in engineering, physics, or material science is typically required for admission. Graduates can pursue academic positions in material research and development or contribute to innovation in sectors including electronics, healthcare, and aerospace.
Ph.D. in Nuclear Physics
Atomic nuclei, nuclear processes, and the fundamental forces driving them are the subjects of a research-focused Ph.D. program in nuclear physics. This curriculum, which usually lasts 3-5 year...
Ph.D. in Nuclear Physics
×Atomic nuclei, nuclear processes, and the fundamental forces driving them are the subjects of a research-focused Ph.D. program in nuclear physics. This curriculum, which usually lasts 3-5 years, blends theoretical analysis with experimental study in fields like radiation, nuclear energy, particle physics, and nuclear structure. Students work on innovative projects that include high-energy physics, nuclear models, and applications in industry, energy, and medicine. A strong research proposal and a M. Sc in physics or a similar discipline are typically prerequisites for admission. Graduates go on to work in national laboratories, academia, or the nuclear technology, medical physics, and energy sectors.
Ph.D. in Laser Physics
The science and technology of lasers, including their creation, use, and interactions with matter, are examined in a research-heavy Ph.D. program in laser physics. The curriculum, which usually las...
Ph.D. in Laser Physics
×The science and technology of lasers, including their creation, use, and interactions with matter, are examined in a research-heavy Ph.D. program in laser physics. The curriculum, which usually lasts 3-5 years, blends theoretical research with hands-on experimental in fields like laser materials, nonlinear optics, quantum electronics, and laser optics. Students study sophisticated laser technologies such as fiber optics, ultrafast lasers, and spectroscopy, as well as fundamentals of light-matter interaction and laser systems. M. Sc( physics) or a similar discipline and a compelling research proposal are prerequisites for admission. Graduates are prepared for jobs in industry, academia, or high-tech research in areas such as materials science, medical devices, and telecommunications.
Ph.D. in Atomic and Molecular Physics
Studying atoms, molecules, and their interactions, as well as how they are used in disciplines like quantum mechanics, spectroscopy, and material science, is the main focus of a Ph.D. program in at...
Ph.D. in Atomic and Molecular Physics
×Studying atoms, molecules, and their interactions, as well as how they are used in disciplines like quantum mechanics, spectroscopy, and material science, is the main focus of a Ph.D. program in atomic and molecular physics. Depending on the status of the study, the program usually takes 3-5 years to finish. Students study subjects like atomic structure, laser-matter interactions, molecular dynamics, and quantum optics through sophisticated experimental and theoretical research. A master's degree in physics or a similar discipline is often required for admission. Graduates of this program are equipped for jobs in physics and related fields in academia, industry, and research.
Ph.D. in Arabic
The Arabic language, literature, linguistics, and cultural studies are the main areas of study for a Ph.D. program in Arabic. Depending on criteria of the university and the extent of the stu...
Ph.D. in Arabic
×The Arabic language, literature, linguistics, and cultural studies are the main areas of study for a Ph.D. program in Arabic. Depending on criteria of the university and the extent of the study, the course usually takes 3-5 years to finish. Along with studying Arabic linguistics and translation, it entails a thorough examination of both classical and contemporary Arabic literature, poetry, prose, and critical theory. Additionally, program provides opportunity to study regional dialects, Arabic rhetoric, and Islamic scriptures. A Master's degree in Arabic or a closely related discipline with significant research potential is typically required of applicants. Graduates support the preservation of Arabic culture and scholarship.
Ph.D. in Bengali
Advanced studies in Bengali language, literature, linguistics, and cultural studies are the main focus of a Ph.D. program in Bengali, which is research-oriented. The 3-5-year degree entails linguis...
Ph.D. in Bengali
×Advanced studies in Bengali language, literature, linguistics, and cultural studies are the main focus of a Ph.D. program in Bengali, which is research-oriented. The 3-5-year degree entails linguistic analysis as well as in-depth study of Bengali literature, poetry, drama, and critical theory, both classical and contemporary. Additionally, students can study translation studies, regional literature, and the sociocultural effects of Bengali. A Master's degree in Bengali or a similar discipline is typically required for admission. The Ph.D. program seeks to develop academics who can preserve the literary and cultural legacy of Bengali-speaking populations while also making creative contributions to the discipline.
Ph.D. in Islamic Studies
A Ph.D. in Islamic Studies is a comprehensive research program that explores various aspects of Islam, including theology, history, philosophy, law (Fiqh), Islamic civilization, and contemporary is...
Ph.D. in Islamic Studies
×A Ph.D. in Islamic Studies is a comprehensive research program that explores various aspects of Islam, including theology, history, philosophy, law (Fiqh), Islamic civilization, and contemporary issues. The program usually spans 3 to 5 years, depending on research progress. Students engage in advanced studies of Islamic texts such as the Quran, Hadith, and classical jurisprudence, while also examining modern interpretations and applications of Islamic principles. Admission typically requires a Master's degree in Islamic Studies or a related field, along with a well-defined research proposal. Graduates are prepared for academic, religious, or cultural leadership roles, contributing to scholarly and community-based initiatives in Islamic thought.
Ph.D. in Islamic Theology
The study of Islamic ideas, beliefs, law, philosophy, and history is explored in depth in the demanding research-based Ph.D. program in Islamic theology. The program, usually lasting 3-5 ...
Ph.D. in Islamic Theology
×The study of Islamic ideas, beliefs, law, philosophy, and history is explored in depth in the demanding research-based Ph.D. program in Islamic theology. The program, usually lasting 3-5 years, gives students the opportunity to concentrate in subjects like Hadith, Islamic law (Fiqh), Sufism, Islamic ethics, or Quranic studies. Typically, candidates must have a solid academic background, a research proposal, and a Master's degree in Islamic Studies or a similar discipline. PhD program places a strong emphasis on creative contributions to Islamic thought, advanced knowledge, and critical thinking. Graduates are equipped for leadership positions in academia, religion, or culture both inside and outside of the Muslim community.
Ph.D. in Urdu
Advanced studies in Urdu language, literature, linguistics, and cultural studies are the main focus of a Ph.D. program in Urdu, which is a research-based doctoral degree. Depending on universi...
Ph.D. in Urdu
×Advanced studies in Urdu language, literature, linguistics, and cultural studies are the main focus of a Ph.D. program in Urdu, which is a research-based doctoral degree. Depending on university and the state of study, the course usually lasts 3-5 years. It entails a thorough examination of Urdu poetry, drama, critical theory, and both classical and contemporary literature. Additionally, students study cultural historiography, translation studies, and language analysis. A Master's degree in Urdu or a closely related discipline, along with compelling research project, is typically required for admission. Program's goal is to develop scholars who can advance Urdu studies knowledge worldwide and conduct unique research.